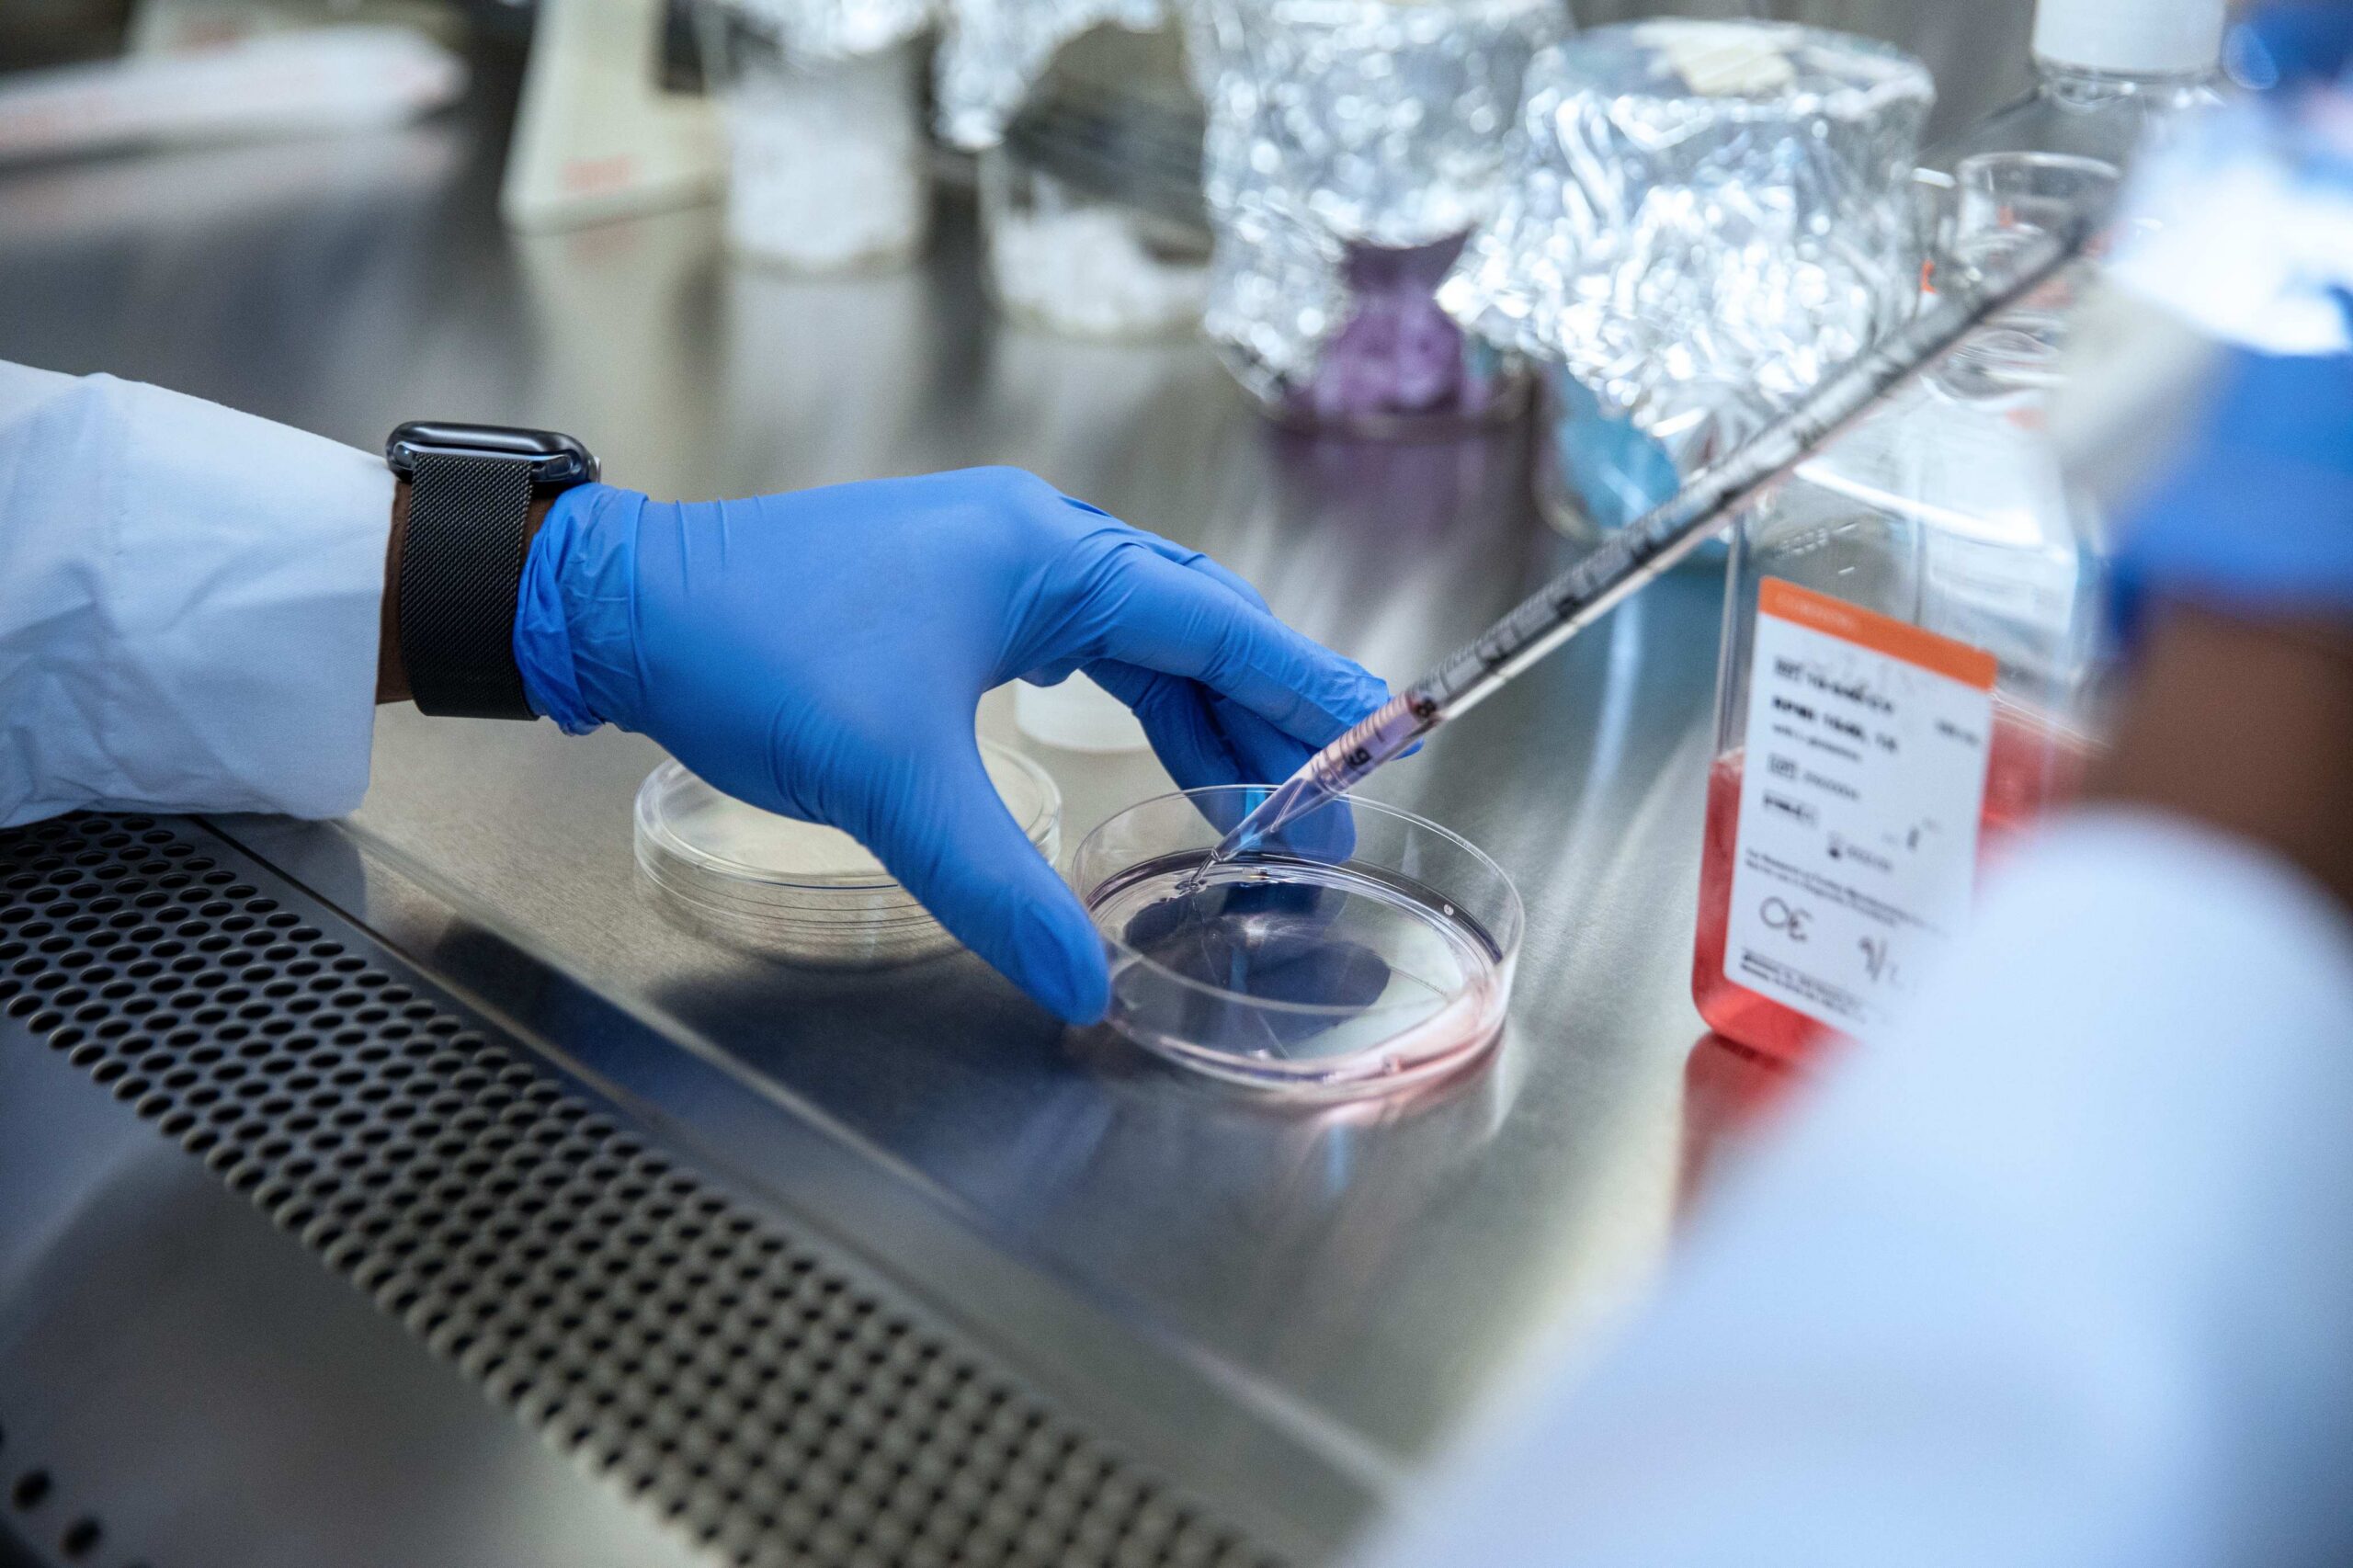
Photograph of a pharmacy student dripping a formula into a petri dish.

Where Your PharmD Degree Meets Your Purpose
Presbyterian College School of Pharmacy offers PharmD specializations through structured concentrations that allow students to tailor their pharmacy education to their career interests. These pharmacy school concentrations—including rural health, research, and innovation and entrepreneurship—help students build advanced skills, explore career pathways, and prepare for diverse roles in modern healthcare.
Innovation and Entrepreneurship Concentration
Change the world of medicine.
Combine creative thinking with your entrepreneurial spirit and love of pharmacy. Our Innovation and Entrepreneurship (IE) program equips you to explore solutions for the various challenges facing pharmacy today. Learn to apply sound business principles to address the healthcare needs of a diverse and dynamic population, resulting in improved health for all.

Concentration Highlights
Earn a nationally renowned certificate through the Kauffman FastTrac®.
Learn the basics of entrepreneurship through the FastTrack Planning the Entrepreneurial Venture™.
Network with and learn from successful entrepreneurs in a variety of fields.
Past programs include:
- “How Can Pharmacists Become Influencers?”
- “Why Advocacy Matters: Independent Pharmacies vs. Big Pharma”
- “Making Failure a Part of Every Successful Business Plan”
- “Opportunities and Challenges of 340B Independent Pharmacy Ownership”
- “Taking the Leap”
- “The Journey Beyond Dispensing in a Community Pharmacy”
- “Non-Traditional Pharmacy Career Path”
- “Tips to Successfully Operate a Pharmacy Store: The Dos and Don’ts of Pharmacy Ownership”
Requirements
P2 Year
Complete PHRM 9020 (Entrepreneurial Development) elective.
Complete the Kauffman Foundation’s “Planning the Entrepreneurial Venture” FastTrac® certificate.
Attend one additional IE event, or other approved offering.
P3 Year
Participate in a business plan competition or bootcamp as determined by the IE program director.
Attend one additional IE event or other approved offering.
P4 Year
Complete an entrepreneurial-focused advanced pharmacy practice experience (APPE) elective rotation (coordinated by PCSP’s Office of Experiential Education).
Stemming from elective and APPE experiences, develop and present a detailed and comprehensive business plan for a new service or improvement to a current service or business operation.
Rural Health Concentration
Make healthcare more accessible.
Become an effective healthcare leader in rural and underserved areas. In collaboration with the SC Area Health Education Consortium (AHEC), the Rural Health Concentration connects you with the tools, training, and resources to provide optimal team-based care to your community.

Concentration Highlights
Topics addressed in this concentration include:
- Social determinants of health
- Health behavior
- Population health
- Epidemiology
- Health promotion
- Disease prevention
Requirements
Year 1
P2 Spring | P3 Fall
- Apply and be accepted to participate in the PCSP Public and Rural Health Concentration and for the AHEC Scholars Program
- Attend AHEC orientation
- Complete AHEC baseline evaluation
- Complete required AHEC online modules
- Complete a total of 40 hours of related didactic activities (through AHEC or PCSP elective)
- Participate in at least one AHEC Interprofessional Team Case Conference (ITCC)
- Complete an IPPE at a qualifying experiential site
Year 2
P3 Spring | P4 Summer | P4 Fall
- Complete required AHEC online modules
- Complete a total of 40 hours of related didactic activities (through AHEC or PCSP elective)
- Participate in at least one AHEC ITCC
- Complete an APPE at a qualifying experiential stie
- Complete AHEC Scholars Capstone, end-of program evaluation, and reflection (must be completed by the end of the P4 spring semester)
Research Concentration
Elevate your pharmaceutical research skills.
Learn how to connect pharmaceutical science with people. The Certificate of Research and Scholarship from PCSP provides a formal, organized framework for learning how to interpret and integrate laboratory and clinical research into your practice. Upon completion, you’ll be able to conduct research with confidence while collaborating with other laboratory scientists and practicing pharmacists.

Concentration Highlights
Throughout the program, you’ll gain the skills to:
- Form relevant clinical research questions
- Search and critique science literature
- Develop your study design
- Hone your analytical methodology
- Understand research ethics
- Explore research funding sources and management
Requirements
P2 Year
Become paired with a mentor for research topic area of interest.
Complete one elective course with research emphasis in the Spring semester or equivalent experience.
Complete at least 2 hours of supplemental education (e.g., professional meeting, online education, Pharmacy Research Summer Intern [PRSI], etc.) or equivalent experience on research (to be approved by the Presbyterian College School of Pharmacy Office of Research and/or concentration mentor).
P3 Year
Complete one elective course with a research emphasis in Fall or Spring Semester or equivalent experience.
Complete at least 3-6 hours of supplemental education (e.g., professional meeting, online education, PRSI etc.) or equivalent experience on the research topic (to be approved by the Presbyterian College School of Pharmacy Office of Research and/or concentration mentor).
Complete applicable trainings including, but not limited to the following:
- Collaborative Institutional Training Initiative (CITI Program)
- Lab safety
- Bloodborne Pathogens
- HIPAA
Select and conduct research on the topic area of interest.
P4 Year
Complete 4 credit hours (1 rotation) of advanced pharmacy practice experience (APPE) in research (to be coordinated by the Office of Experiential Education in conjunction with the Office of Research).
Present a poster presentation (e.g., Honors Day, professional meeting) on the research project.
Submit a written manuscript for publication describing the research project and current outcomes.
*Students may complete only 1 independent study for course credit.
** Other venue(s) may be appropriate.